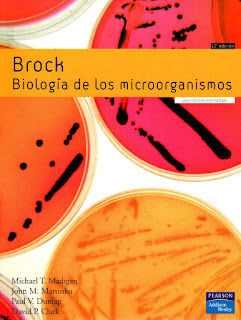

Editorial: Pearson
Fecha de Edición: 2009
ISBN: 9788478290970
Páginas: 1296
Descargaractualizado 19/11/2019
Descargar actualizado 16/10/2020
ÍNDICE
Unidad 1 Principios de microbiología
Capítulo 1 Microorganismos y microbiología
Capítulo 2 Un breve viaje por el mundo microbiano
Capítulo 3 Química de los componentes celulares
Capítulo 4 Estructura y función celular en Bacterias y Arqueas
Capítulo 5 Nutrición, cultivo y metabolismo microbiano
Capítulo 6 Crecimiento microbiano
Unidad 2 Biología molecular de los organismos
Capítulo 7 Fundamentos de biología molecular
Capítulo 8 Bioloía molecular de arqueas y eucariotas
Capítulo 9 Regulación de la expresión génica
Capítulo 10 Una visión rápida de los virus y la virología
Capítulo 11 Fundamentos de genética bacteriana
Capítulo 12 Ingeniería genética
Capítulo 13 Genómica microbiana
Unidad 3 La diversidad microbiana
Capítulo 14 Evolución y sistemática microbiana
Capítulo 15 Dominio Bacteria: las probacterias
Capítulo 16 Dominio Bacteria: grampositivas y otras bacterias
Capítulo 17 Dominio Archea
Capítulo 18 Biología celular y microorganismos eucariotas
Capítulo 19 Diversidad viral
Unidad 4 Diversidad metabólica y ecología microbiana
Capítulo 20 Diversidad metabólica: fototrofía, autotrofía, quimiolitotrofía y fijación del nitrógeno
Capítulo 21 Diversidad metabólica: catabolismo de los compuestos orgánicos
Capítulo 22 Métodos de ecología microbiana
Capítulo 23 Ecosistemas microbianos
Capítulo 24 Ciclo de los nutrientes, biorremediación y símbiosis
Unidad 5 Microbiología aplicada
Capítulo 25 Microbiología industrial
Capítulo 26 Biotecnología
Unidad 6 Agentes antimicrobianos y patogenicidad
Capítulo 27 Control del crecimiento microbiano
Capítulo 28 Interacciones d elos microorganismos con la especie humana
Unidad 7 Inmunología
Capítulo 29 Principios esenciales de inmunología
Capítulo 30 La inmunidad en la defensa del hospedador y en la enfermedad
Capítulo 31 Inmunología molecular
Unidad 8 Diagnóstico y seguimiento de las enfermedades infecciosas
Capítulo 32 Microbiología e inmunología diagnóstica
Capítulo 33 Epidemiología
Unidad 9 Enfermedades microbianas
Capítulo 34 Enfermedades microbianas transmitidas de persona a persona
Capítulo 35 Enfermedades transmitidas por vectores y por microorganismos del suelo
Capítulo 36 Tratamiento de aguas residuales, potabilización de aguas y enfermedades microbianas transmitidas por el agua
Capítulo 37 Conservación de los alimentos y enfermedades microbianas transmitidas por los alimentos
Apéndice 1
Cálculos de energía en bioenergética microbiana
Apéndice 2
Manual de Bergey de bacteriología sistemática, segunda edición
Glosario
Índice analítico
No hay comentarios:
Publicar un comentario